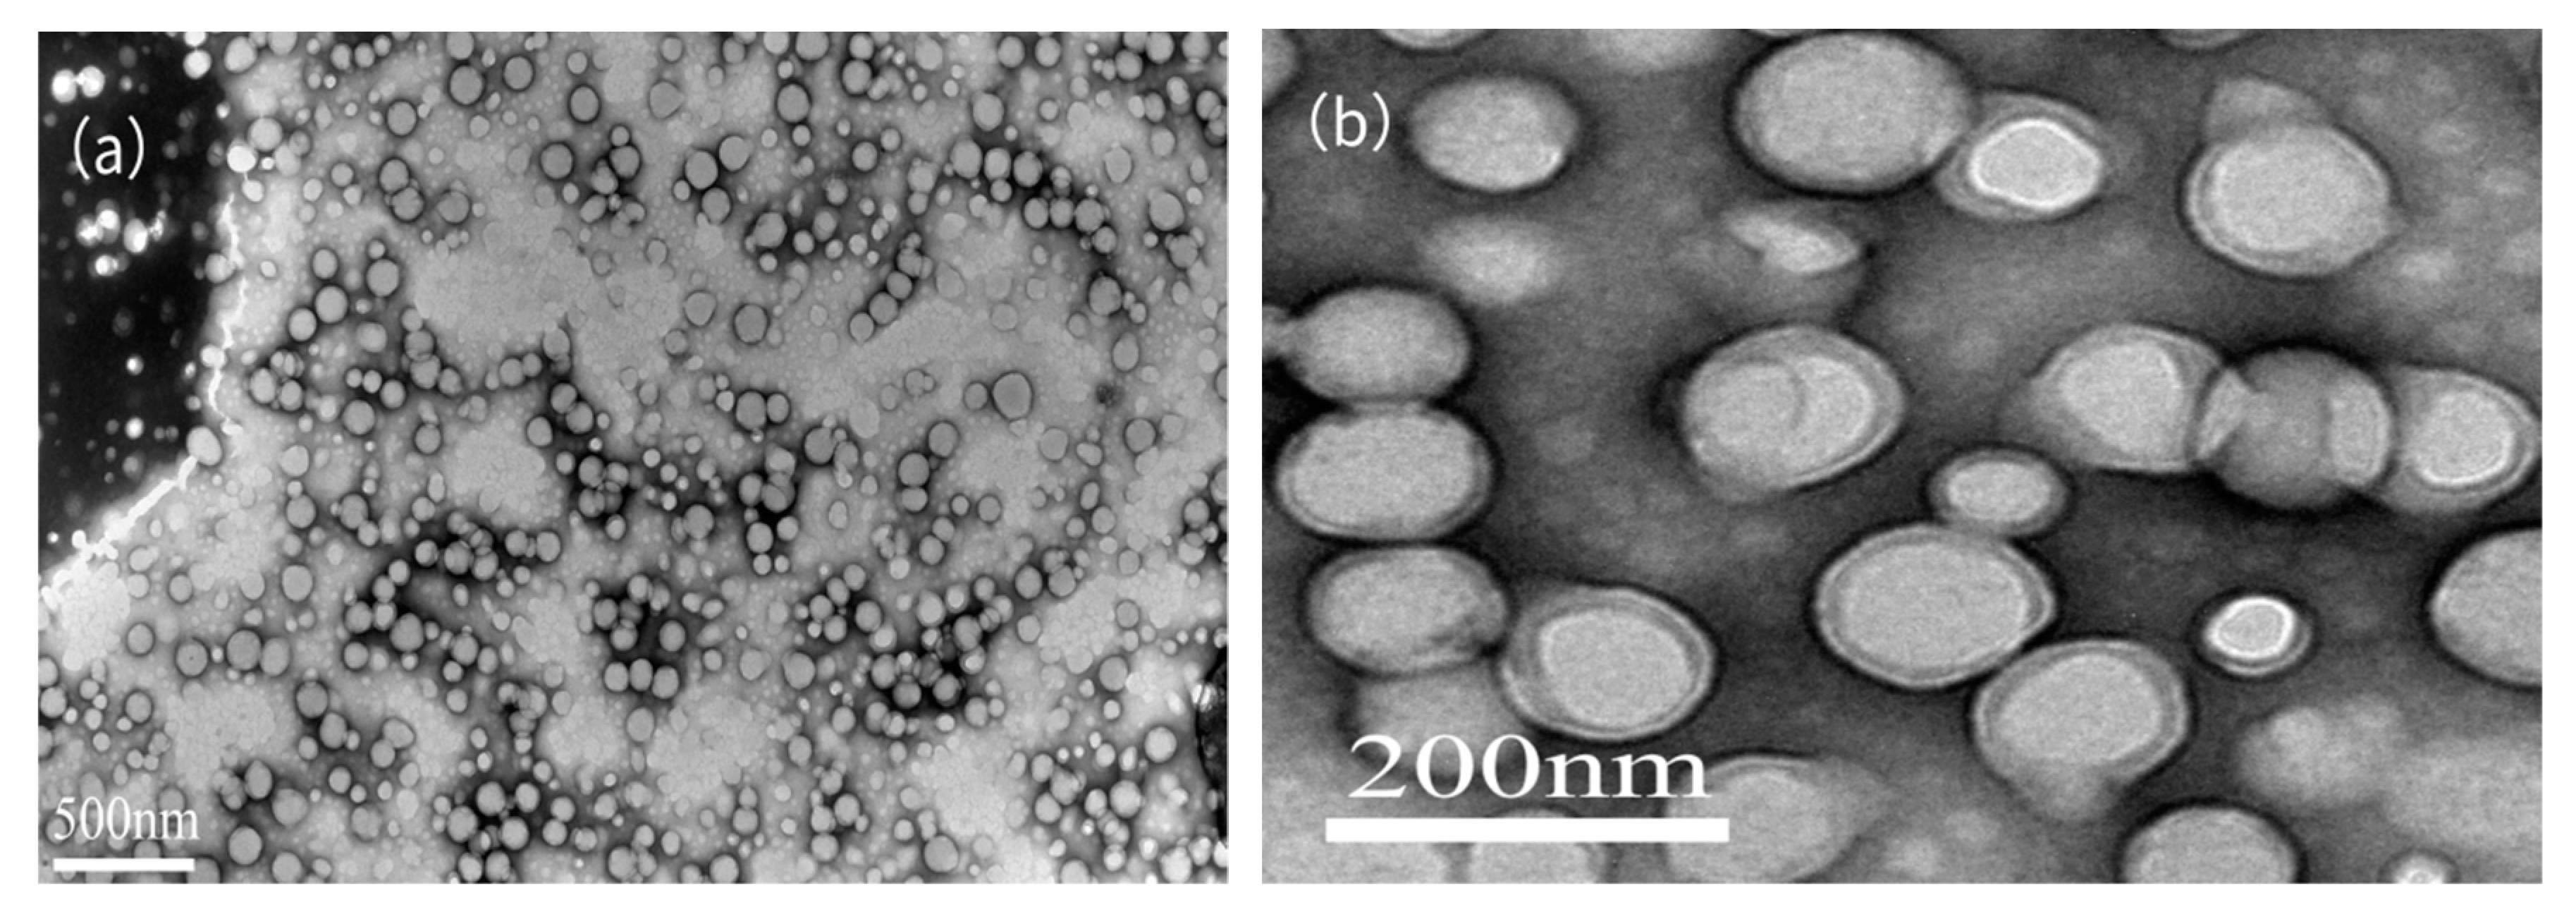
Materials 13 00865 g008 Materials 13 00865 g008

Preparation and Characterization of Soap-Free Vinyl Acetate/Butyl Acrylate Copolymer Latex
Abstract
1. Introduction
2. Materials and Methods
2.1. Materials
2.2. Preparation of Emulsion
2.3. Characterization
2.3.1. Conversion Rate
2.3.2. Polymerization Stability
2.3.3. Water Absorption Rate
2.3.4. Mechanical Stability
2.3.5. Ionic Stability
2.3.6. Contact Angle
2.3.7. FTIR
2.3.8. TEM
2.3.9. DSC
2.3.10. TG
2.3.11. Latex Particle Size Measurement
3. Results and Discussion
3.1. Effect of the DNS-86 Amount on Polymerization
3.2. Effect of DNS-86 on Mechanical and Ionic Stability of Emulsion
3.3. Effect of the DNS-86 Amount on Water Resistance of the Latex Film
3.4. Effect of the DNS-86 Amount on Size of Latex Particles
3.5. FT-IR
3.6. DSC
3.7. TGA
3.8. TEM
4. Conclusions
- In this study, a soap-free VAc/BA copolymer was successfully prepared by the semi-continuous and pre-emulsification polymerization method. When the DNS-86 amount is 4 wt %, the monomer conversion is 98.64%, the coagulation ratio is 0.34% and the latex has better ionic stability.
- Compared with the PVAc latex prepared with OP-10, the latex film prepared with DNS-86 has a lower water absorption rate, which means that the addition of reactive emulsifier significantly improves the water resistance of the latex film.
- FTIR demonstrated that each monomer takes part in copolymerization. A distinguishable phase separation of core phase and shell phases was observed obviously by TEM. DSC showed that the copolymer had two Tg, which is consistent with the design of the core–shell structure. TG indicated that the large-volume flexible side group of DNS-86 raised the thermal stability of the latex.
Author Contributions
Funding
Conflicts of Interest
References
- Mao, J.; Zhuang, Q.; Peng, S.; Liu, Q.; Qian, J. Effect of modified phenolic resin on crosslinked network and performances of polyvinyl acetate blending emulsion. J. Appl. Polym. Sci. 2018, 135, 46448. [Google Scholar] [CrossRef]
- Lu, J.; Easteal, A.J.; Edmonds, N.R. Crosslinkable poly(vinyl acetate) emulsions for wood adhesive. Pigment Resin Technol. 2011, 40, 161–168. [Google Scholar] [CrossRef]
- Geng, S.; Shah, F.U.; Liu, P.; Antzutkin, O.N.; Oksman, K. Plasticizing and crosslinking effects of borate additives on the structure and properties of poly(vinyl acetate). RSC Adv. 2017, 7, 7483–7491. [Google Scholar] [CrossRef]
- Desmet, G.B.; Marien, Y.W.; Van Steenberge, P.H.M.; D’Hooge, D.R.; Reyniers, M.-F.; Marin, G.B. Ab initio based kinetic monte carlo analysis to unravel the propagation kinetics in vinyl acetate pulsed laser polymerization. Polym. Chem. 2017, 8, 7143–7150. [Google Scholar] [CrossRef]
- Gong, Y.; Shao, T.; Wang, X.; Zhang, X.; Sun, Z.; Chen, L. Preparation and characterisation of modified vac-veova10 latex. Pigment Resin Technol. 2019, 48, 210–215. [Google Scholar] [CrossRef]
- Jiang, B.Q.; Hu, S.F.; Zeng, J.N.; Wang, M.W. Copolymerization of organosilicone-veova10-vac emulsion modified with protective colloid of pam-peg. Adv. Mater. Res. 2010, 168–170, 2060–2064. [Google Scholar] [CrossRef]
- Abdollahi, M.; Massoumi, B.; Yousefi, M.R.; Ziaee, F. Free-radical homo- and copolymerization of vinyl acetate and n-butyl acrylate: Kinetic studies by online 1h nmr kinetic experiments. J. Appl. Polym. Sci. 2012, 123, 543–553. [Google Scholar] [CrossRef]
- Zhang, Y.; Pang, B.; Yang, S.; Fang, W.; Yang, S.; Yuan, T.Q.; Sun, R.C. Improvement in wood bonding strength of poly (vinyl acetate-butyl acrylate) emulsion by controlling the amount of redox initiator. Materials 2018, 11, 89. [Google Scholar] [CrossRef]
- Ovando-Medina, V.M.; Díaz-Flores, P.E.; Peralta, R.D.; Mendizábal, E.; Cortez-Mazatan, G.Y. Semicontinuous heterophase copolymerization of vinyl acetate and butyl acrylate. J. Appl. Polym. Sci. 2012, 127, 2458–2464. [Google Scholar] [CrossRef]
- Berber, H.; Tamer, Y.; Yildirim, H. The effects of feeding ratio on final properties of vinyl acetate-based latexes via semi-continuous emulsion copolymerization. Colloid Polym. Sci. 2017, 296, 211–221. [Google Scholar] [CrossRef]
- French, M.D. Mechanism of vinyl acetate emulsion polymerization. J. Polym. Sci. 2010, 32, 395–411. [Google Scholar] [CrossRef]
- Liu, H.; Bian, J.; Wang, Z.; Hou, C.J. Synthesis and characterization of waterborne fluoropolymers prepared by the one-step semi-continuous emulsion polymerization of chlorotrifluoroethylene, vinyl acetate, butyl acrylate, veova 10 and acrylic acid. Molecules 2017, 22, 184. [Google Scholar] [CrossRef] [PubMed]
- Dai, M.; Zhang, Y.; He, P. Preparation and characterization of stable and high solid content st/ba emulsifier-free latexes in the presence of amps. Polym. Bull. 2010, 67, 91–100. [Google Scholar] [CrossRef]
- Zhang, Y.; Wang, B.; Dai, M.; Pan, S.; Zhang, F.; He, P. Studies on the preparation of stable and high solid content emulsifier-free poly(mma/ba/hea) latex with the addition of amps and characterization of the obtained copolymers. J. Macromol. Sci. Part A 2011, 48, 409–415. [Google Scholar] [CrossRef]
- Xu, G.; Deng, L.; Wen, X.; Pi, P.; Zheng, D.; Cheng, J.; Yang, Z. Synthesis and characterization of fluorine-containing poly-styrene-acrylate latex with core–shell structure using a reactive surfactant. J. Coat. Technol. Res. 2010, 8, 401–407. [Google Scholar] [CrossRef]
- Wang, J.; Zeng, X.-R.; Li, H.-Q. Preparation and characterization of soap-free fluorine-containing acrylate latex. J. Coat. Technol. Res. 2009, 7, 469–476. [Google Scholar] [CrossRef]
- Ovando-Medina, V.M.; Peralta, R.D.; Mendizábal, E.; Martínez-Gutiérrez, H.; Corona-Rivera, M.A. Microemulsion copolymerization of vinyl acetate and butyl acrylate using a mixture of anionic and non-ionic surfactants. Polym. Bull. 2010, 66, 133–146. [Google Scholar] [CrossRef]
- Urquiola, M.B.; Dimonie, V.L.; Sudol, E.D.; El-Aasser, M.S. Emulsion polymerization of vinyl acetate using a polymerizable surfactant. Ii. Polymerization mechanism. J. Polym. Sci. Part A Polym. Chem. 1992, 30, 2619–2629. [Google Scholar] [CrossRef]
- Schoonbrood, H.A.S.; Asua, J.M. Reactive surfactants in heterophase polymerization. 9.†optimum surfmer behavior in emulsion polymerization. Macromolecules 1997, 30, 6034–6041. [Google Scholar] [CrossRef]
- Sarkar, A.; Jayaram, R.V. A comparative study of properties of acrylic based water-borne polymers using various surfactants for adhesive applications. Polym. Sci. Ser. B 2018, 60, 629–637. [Google Scholar] [CrossRef]
- Mingyue, Z.; Weihong, Q.; Hongzhu, L.; Yingli, S. Synthesis of a novel polymerizable surfactant and its application in the emulsion polymerization of vinyl acetate, butyl acrylate, veova 10, and hexafluorobutyl methacrylate. J. Appl. Polym. Sci. 2008, 107, 624–628. [Google Scholar] [CrossRef]
- Sun, Y.; Qiao, W.; Liu, H. Synthesis of a novel series of polymerizable surfactants and application in emulsion polymerization. Polym. Adv. Technol. 2008, 19, 1164–1167. [Google Scholar] [CrossRef]
- Zhang, Y.; Pan, S.; Ai, S.; Liu, H.; Wang, H.; He, P. Semi-continuous emulsion copolymerization of vinyl acetate and butyl acrylate in presence of amps. Iran. Polym. J. 2013, 23, 103–109. [Google Scholar] [CrossRef]
- Dossi, M.; Liang, K.; Hutchinson, R.A.; Moscatelli, D. Investigation of free-radical copolymerization propagation kinetics of vinyl acetate and methyl methacrylate. J. Phys. Chem. B 2010, 114, 4213–4222. [Google Scholar] [CrossRef] [PubMed]
- Bijlard, A.C.; Winzen, S.; Itoh, K.; Landfester, K.; Taden, A. Alternative pathway for the stabilization of reactive emulsions via cross-linkable surfactants. ACS Macro Lett. 2014, 3, 1165. [Google Scholar] [CrossRef]
- Zhong, L.; Zhou, C.; Che, R.; Lei, J. Preparation and adhesion property of a low temperature cross-linkable vinyl acetate-acrylate copolymer latex. Polym. Plast. Technol. Eng. 2010, 49, 1515–1520. [Google Scholar] [CrossRef]
- Bai, L.; Huan, S.; Zhang, X.; Jia, Z.; Gu, J.; Li, Z. Rational design and synthesis of transition layer-mediated structured latex particles with poly(vinyl acetate) cores and poly(styrene) shells. Colloid Polym. Sci. 2017, 295, 353–362. [Google Scholar] [CrossRef]
- Goodall, A.R.; Wilkinson, M.C.; Hearn, J. Mechanism of emulsion polymerization of styrene in soap-free systems. J. Polym. Sci. Polym. Chem. Ed. 1977, 15, 2193–2218. [Google Scholar] [CrossRef]
- Zeng, N.; Yu, Y.; Chen, J.; Meng, X.; Peng, L.; Dan, Y.; Jiang, L. Facile synthesis of branched polyvinyl acetate via redox-initiated radical polymerization. Polym. Chem. 2018, 9, 3215–3222. [Google Scholar] [CrossRef]
- Jahanzad, F. Some comparative aspects of particle formation and rate of reaction in emulsion polymerization of vinyl acetate and butyl acrylate. J. Appl. Polym. Sci. 2010, 117, 84–90. [Google Scholar] [CrossRef]
- Gibbs, J.H.; Dimarzio, E.A. Nature of the glass transition and the glassy state. J. Chem. Phys. 1958, 28, 373–383. [Google Scholar] [CrossRef]
- Dimarzio, E.A.; Gibbs, J.H. Glass temperature of copolymers. J. Polym. Sci. 1959, 40, 121–131. [Google Scholar] [CrossRef]
- Mackenzie, J.D.; Rice, S.A. Modern Aspects of the Vitreous State; Butterworths: London, UK, 1962. [Google Scholar]
- Holland, B.J.; Hay, J.N. The thermal degradation of poly(vinyl acetate) measured by thermal analysis–fourier transform infrared spectroscopy. Polymer 2002, 43, 2207–2211. [Google Scholar] [CrossRef]
- Rimez, B.; Rahier, H.; Van Assche, G.; Artoos, T.; Biesemans, M.; Van Mele, B. The thermal degradation of poly(vinyl acetate) and poly(ethylene-co-vinyl acetate), part i: Experimental study of the degradation mechanism. Polym. Degrad. Stab. 2008, 93, 800–810. [Google Scholar] [CrossRef]

| VAc | BA | AA | DNS-86 | DAAM | Water | APS | PVA | ADH | |
|---|---|---|---|---|---|---|---|---|---|
| Component I/g | 30 | 0 | 0 | 0.3–1.2 | 0 | 75 | 0 | 6 | 0 |
| Addition/g | 0 | 0 | 0 | 0 | 0 | 5 | 0.24 | 0 | 0 |
| Component II/g | 60 | 30 | 1.2 | 0.9–3.6 | 2.4 | 110 | 0 | 0 | 0 |
| Addition/g | 0 | 0 | 0 | 0 | 0 | 10 | 0.48 | 0 | 2.4 |
| Total/g | 90 | 30 | 1.2 | 1.2–4.8 | 2.4 | 200 | 0.72 | 6 | 2.4 |
| Sample | Amount of DNS-86/wt % | 5% OP-10 (1) | ||||
|---|---|---|---|---|---|---|
| 1 | 2 | 3 | 4 | 5 | ||
| Mechanical stability | × | × | √ | √ | √ | √ |
| Ca2+ stability | × | × | √ | √ | √ | × |
| Sample | Amount of DNS-86/wt % | 5% OP-10 | ||||
|---|---|---|---|---|---|---|
| 1 | 2 | 3 | 4 | 5 | ||
| Water absorption rate/% | 20.18 | 16.92 | 13.47 | 6.84 | 11.49 | 26.81 |
| Sample | First Degradation Temperature (°C) | Secondary Degradation Temperature (°C) | ||||
|---|---|---|---|---|---|---|
| T0-1 | Tp-1 | Tf-1 | T0-2 | Tp-2 | Tf-2 | |
| 4%DNS-86 | 293.5 | 327.9 | 340.1 | 375.3 | 445.3 | 510.7 |
| 5%OP-10 | 280.9 | 325.1 | 333.5 | 374.8 | 444.1 | 509.5 |
© 2020 by the authors. Licensee MDPI, Basel, Switzerland. This article is an open access article distributed under the terms and conditions of the Creative Commons Attribution (CC BY) license (http://creativecommons.org/licenses/by/4.0/).
Share and Cite
Zhang, Y.; Bei, W.; Qin, Z. Preparation and Characterization of Soap-Free Vinyl Acetate/Butyl Acrylate Copolymer Latex. Materials 2020, 13, 865. https://doi.org/10.3390/ma13040865
Zhang Y, Bei W, Qin Z. Preparation and Characterization of Soap-Free Vinyl Acetate/Butyl Acrylate Copolymer Latex. Materials. 2020; 13(4):865. https://doi.org/10.3390/ma13040865
Chicago/Turabian StyleZhang, Yifu, Wenkai Bei, and Zhiyong Qin. 2020. "Preparation and Characterization of Soap-Free Vinyl Acetate/Butyl Acrylate Copolymer Latex" Materials 13, no. 4: 865. https://doi.org/10.3390/ma13040865
APA StyleZhang, Y., Bei, W., & Qin, Z. (2020). Preparation and Characterization of Soap-Free Vinyl Acetate/Butyl Acrylate Copolymer Latex. Materials, 13(4), 865. https://doi.org/10.3390/ma13040865
